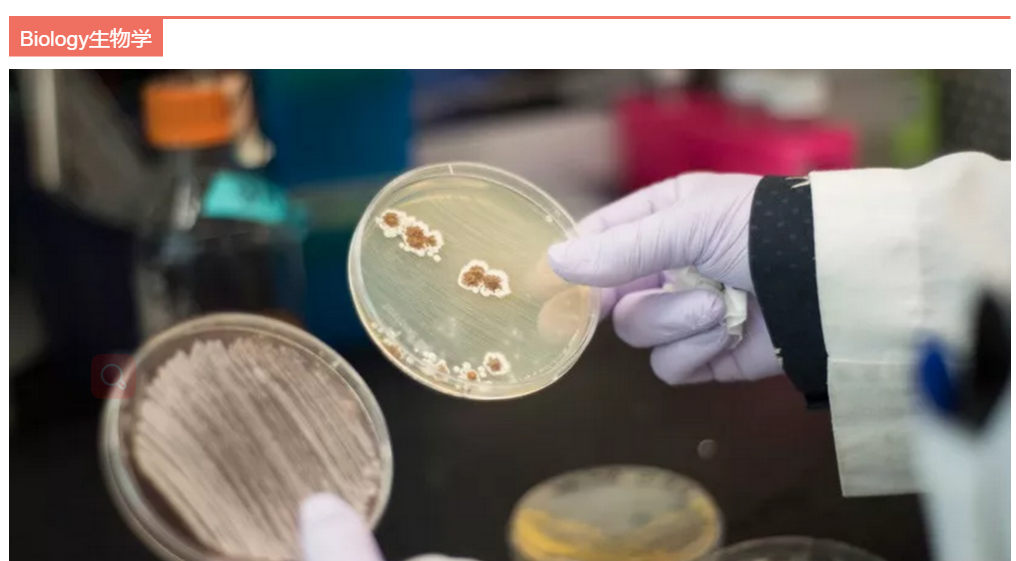

当你觉得那个专业很难申请,离你很远,有时候并不是你不够优秀,而是那个专业其实不适合你。专业排名更多时候是一个参考,找到最适合自己的才是我们的终极目标,这样离你的梦就更进了一步。








阅读:65 收藏:0 评论:0 点赞:0
3秒免费留学费用评估
提前算一算,出国留学要花多少钱?
当你觉得那个专业很难申请,离你很远,有时候并不是你不够优秀,而是那个专业其实不适合你。专业排名更多时候是一个参考,找到最适合自己的才是我们的终极目标,这样离你的梦就更进了一步。